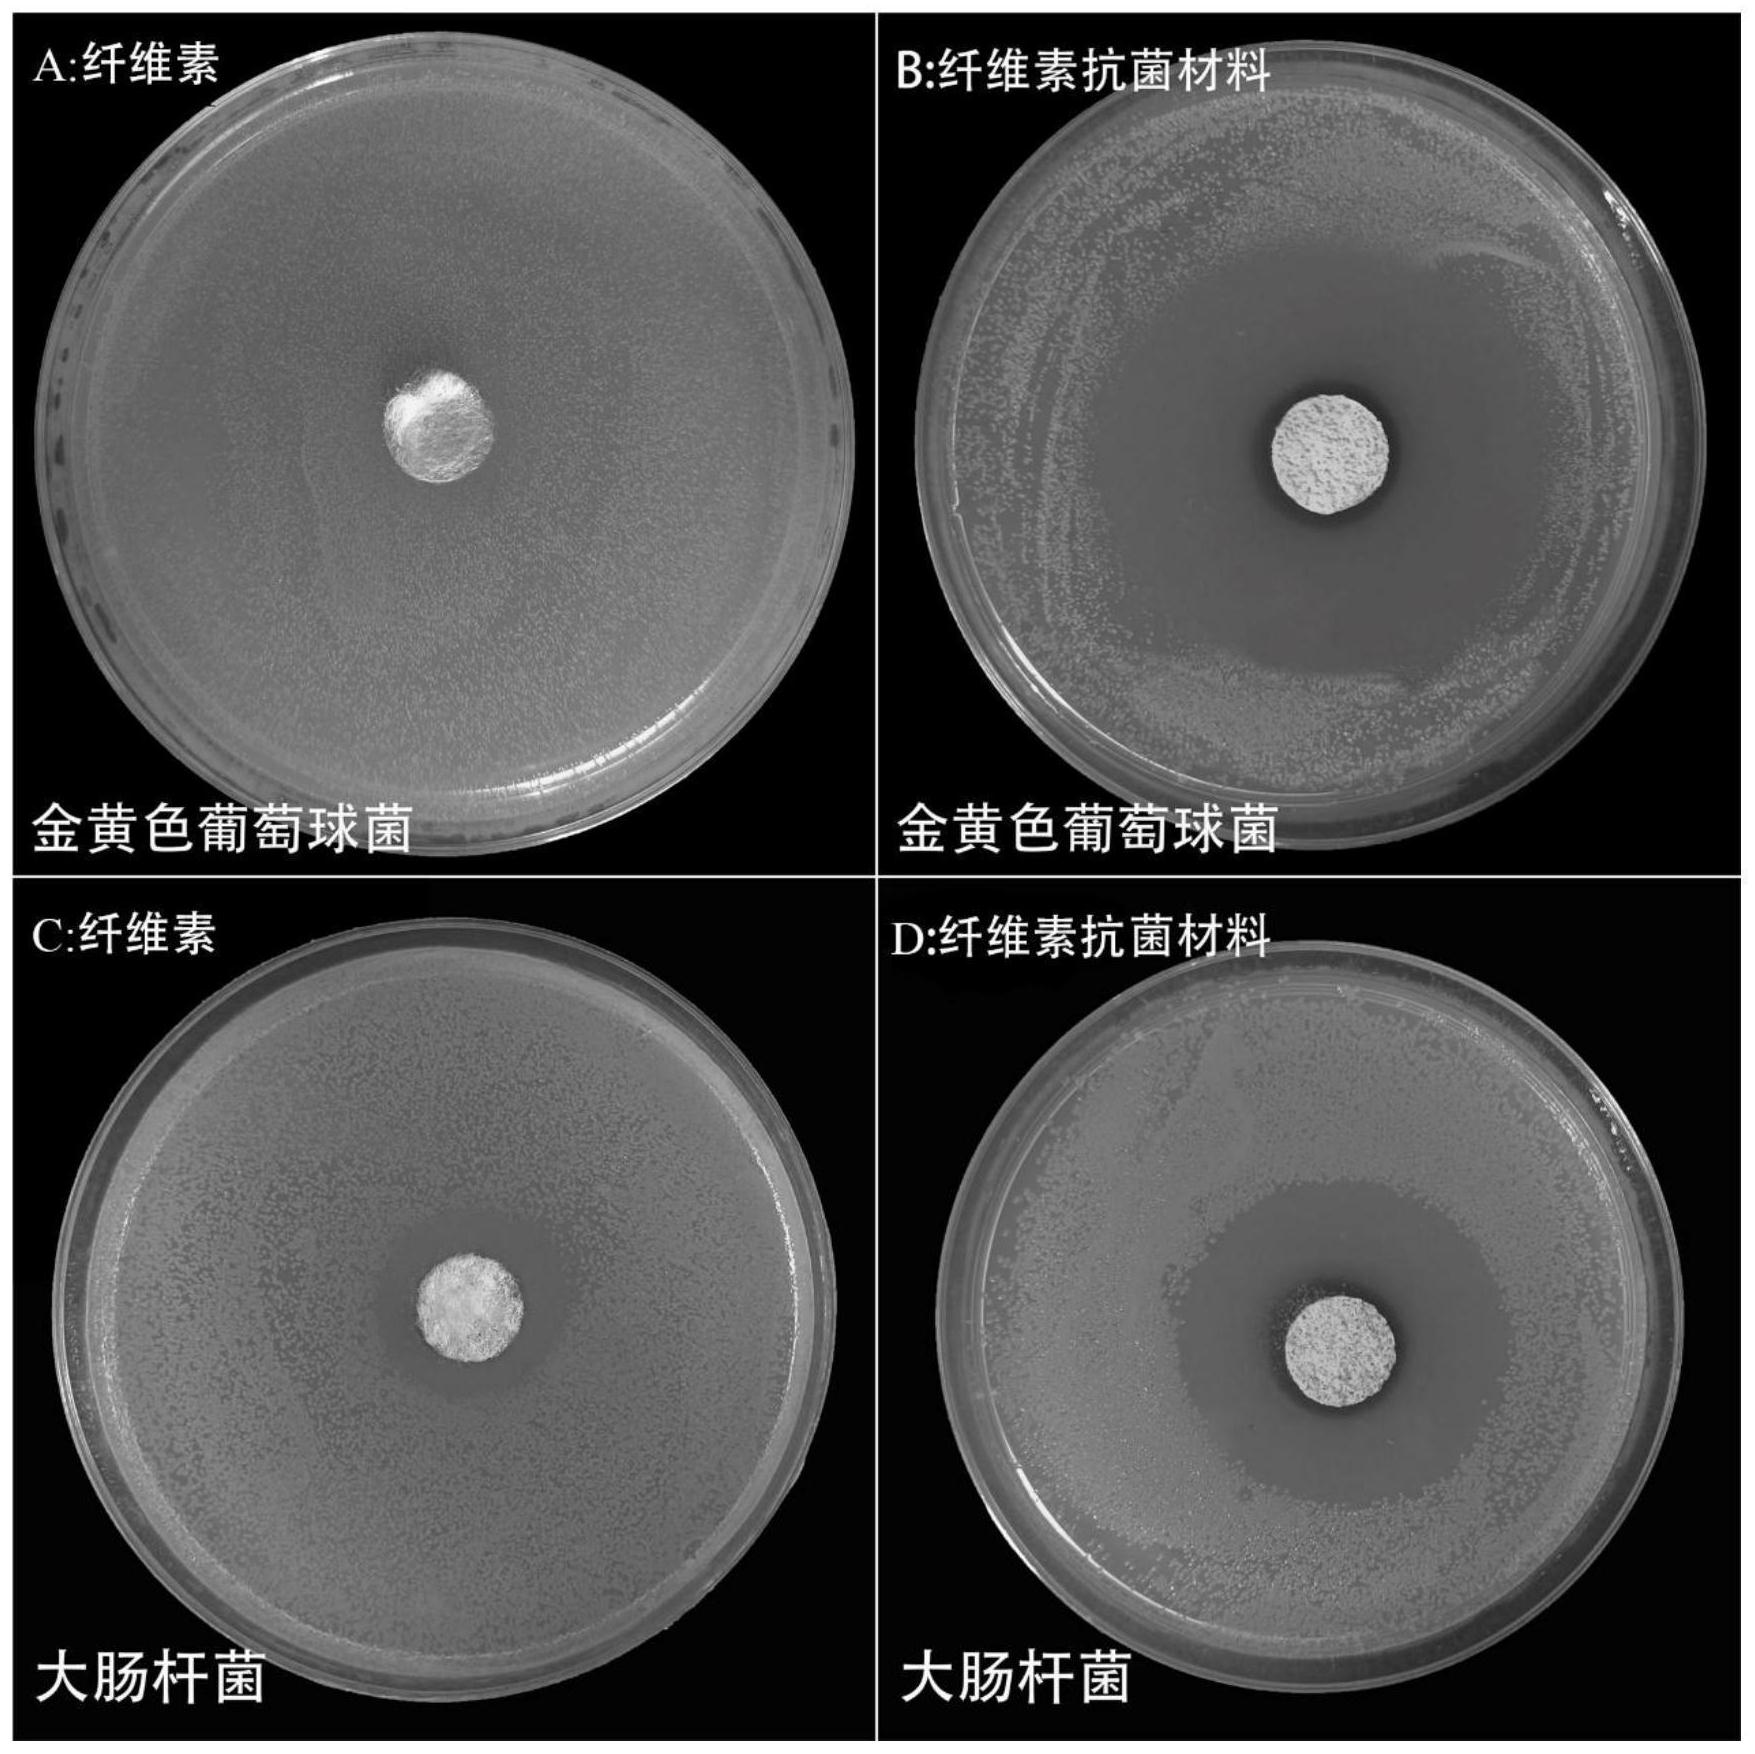
一种具有赖氨酸接枝N-卤胺型席夫碱结构的纤维素抗菌材料及其制备方法

一种具有赖氨酸接枝N-卤胺型席夫碱结构的纤维素抗菌材料及其制备方法
注:上述费用仅包含专利权利转让费用,不包含专利年费或因年费未及时缴纳产生的滞纳金、恢复费。专利年费是专利权人依照专利法规定,自被授予专利权的当年开始,在专利权有效期内逐年应向专利局缴纳的费用。由于出售的专利类型、专利年限以及专利权人是否满足国家费用减缓的条件均会影响具体年费金额,需根据购买专利的实际情况进行缴纳。缴纳年费以及滞纳金、恢复费需单独和平台顾问确认且不属于下单后加价行为,故无法适用保障。
专利申请号:
CN202111239746.4
专利类型:
发明专利
技术分类:
C08B15/06(2006.01)I
专利有效期:
2041-10-25
友情提示:该资源未保障“真” “价”,付款前请核实资源真实性与价格。
在线咨询

- 该资源已获得保障和赔付:
- 转让不成功退款退
- 转让超期必赔时
- 该资源未获得保障和赔付:
- 资源不保真必赔真
- 下单后加价必赔价
专利信息
专利名称:一种具有赖氨酸接枝N-卤胺型席夫碱结构的纤维素抗菌材料及其制备方法
商品编号:5661380
复制
申请日期:2021-10-25
公开/公告号:CN113943377A
授权公告日/公开日:2022-01-18
申请/专利权人:
长春***学
发明/设计人:
肖**
主分类号:C08B15/06(2006.01)I
IPC分类号:C08B15/06;A01N43/50;A01P3/00;A01P1/00
说明书摘要免费下载摘要
本发明提供一种具有赖氨酸接枝N‑卤胺型席夫碱结构的纤维素抗菌材料及其制备方法,属于抗菌材料的制备方法技术领域。该抗菌材料是通过酰胺反应将赖氨酸与N‑卤胺结合在一起,同时通过席夫碱反应将赖氨酸接枝N‑卤胺固定到纤维素上,制备了一种具有氨基酸席夫碱杀菌能力和N‑卤胺杀菌能力的纤维素抗菌材料。本发明还提供上述制备方法得到的具有赖氨酸接枝N‑卤胺型席夫碱结构的纤维素抗菌材料。本发明所述的纤维素抗菌材料具有更强的抗菌效果和抗菌活性,其氯含量高达3.62%,能够在5min内杀死100.00%的金黄色葡萄球菌和大肠杆菌。
转让流程

提出需求
提出您的专利需求
顾问一对一服务
顾问一对一服务

顾问匹配
顾问匹配资源库
快速确定优质专利
快速确定优质专利

签订合同
签订专利转让协议
成功付款
成功付款

递交申请
准备转让资料
国知局审查办理
国知局审查办理

领取证书
获得专利权,投入使用
所需资料
买方提供资料

个人身份证

公司或个体营业执照
购买后获得证书

专利证书

专利登记簿副本

手续合格通知书
平台优势
常见问题
购买专利需要什么资料?
一种具有赖氨酸接枝N-卤胺型席夫碱结构的纤维素抗菌材料及其制备方法专利,专利类型:发明授权,技术分类是:C08B15/06(2006.01)I,购买一种具有赖氨酸接枝N-卤胺型席夫碱结构的纤维素抗菌材料及其制备方法专利,需要申请人和发明人的基础信息,还需提供一种具有赖氨酸接枝N-卤胺型席夫碱结构的纤维素抗菌材料及其制备方法专利的详细信息。
专利交易转让时间是多久?
专利权转让期限一般是2~6个月的时间获得专利转让通知书,在转让之前双方需要签订转让合同即可,一种具有赖氨酸接枝N-卤胺型席夫碱结构的纤维素抗菌材料及其制备方法专利具体的操作步骤,可以联系八戒数字交易的客服一对一服务。
相似专利
换一换